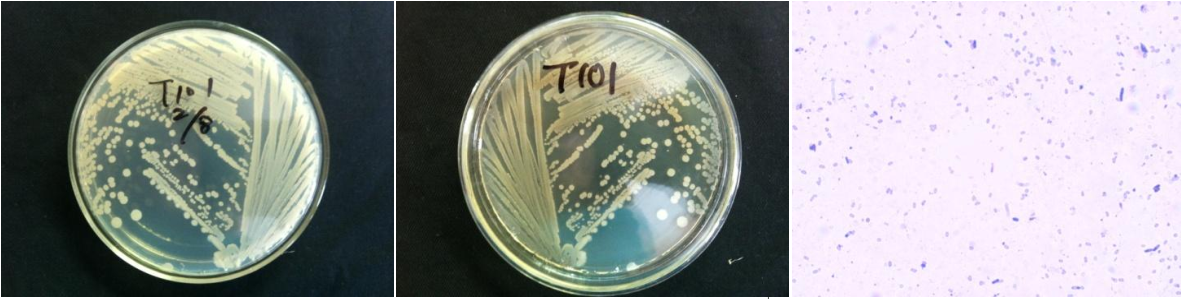

Loading...
| StrainNO | B387 |
| Classification | Bacillus |
| 16s rDNA sequence | CAAAAGGTTACCTCACCGACTTCGGGTGTTACAAACTCTCGTGGTGTGACGGGCGGTGTGTACAAGACCCGGGAACGTATTCACC GCGGCATGCTGATCCGCGATTACTAGCGATTCCGGCTTCATGTAGGCGAGTTGCAGCCTACAATCCGAACTGAGAATGGTTTTAT GGGATTGGCTTAACCTCGCGGTTTTGCAGCCCTTTGTACCATCCATTGTAGCACGTGTGTAGCCCAGGTCATAAGGGGCATGATG ATTTGACGTCATCCCCACCTTCCTCCGGTTTGTCACCGGCAGTCACCTTAGAGTGCCCAACTGAATGCTGGCAACTAAGATCAAG GGTTGCGCTCGTTGCGGGACTTAACCCAACATCTCACGACACGAGCTGACGACAACCATGCACCACCTGTCACTCTGTCCCCGAA GGGAACCTTCTATCTCTAGAAGTAGCAGAGGATGTCAAGACCTGGTAAGGTTCTTCGCGTTGCTTCGAATTAAACCACATGCTCC ACCGCTTGTGCGGGTCCCCGTCAATTCCTTTGAGTTTCAGTCTTGCGACCGTACTCCCCAGGCGGAGTGCTTAATGCGTTTGCTG CAGCACTAAAGGGCGGAAACCCTCTAACACTTAGCACTCATCGTTTACGGCGTGGACTACCAGGGTATCTAATCCTGTTCGCTCC CCACGCTTTCGCGCCTCAGCGTCAGTTACAGACCAGAGAGCCGCCTTCGCCACTGGTGTTCCTCCACATCTCTACGCATTTCACC GCTACACGTGGAATTCCGCTCTCCTCTTCTGCACTCAAGTTCCCCAGTTTCCAATGACCCTCCACGGTTGAGCCGTGGGCTTTCA CATCAGACTTAAGGAACCGCCTGCGCGCGCTTTACGCCCAATAATTCCGGACAACGCTTGCCACCTACGTATTACCGCGGCTGCT GGCACGTAGTTAGCCGTGGCTTTCTGGTTAGGTACCGTCAAGGTACCTGCTTATTTAACAGGTACTTGTTCTTCCCTAACAACAG AGCTTTACGATCCGAAAACCTTCATCACTCACGCGGCGTTGCTCCGTCAGACTTTCGTCCATTGCGGAAGATTCCCTACTGCTGC CTCCCGTAGGAGTCTGGGCCGTGTCTCAGTCCCAGTGTGGCCGATCACCCTCTCAGGTCGGCTACGCATCGTCGCCTTGGTGAGC CGTTACCTCACCAACTAGCTAATGCGCCGCGGGCCCATCCTTGAGTGGTAGCTAAAAGCCACCTTCTAACATATCCTCATGCGAA GATATGTGTTATCCGGTATTAGCTCCGGTTTCCCGGAGTTATCCCCGTCTCAAGGGCAGGTTGCCCACGTGTTACTCACCCGTCC GCCGCTAAGTTTTGAAAAGCAAGCTTTTCAAAACTTCGCTCGACTT |
| Strain Morphology Photos | |
| Morphological Description | round;clam white;edge neatly;flat;slippy;sticky;Rod;having spore;spore mesophytic |